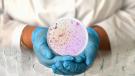

Není antibiotikum jako antibiotikum
Jsou některá antibiotika (ATB) vhodnější?
Určitě ano. V případě běžných a obvykle nezávažných infekcí, které léčíme ambulantně, je naší snahou vždy použít antibiotika s co nejužším spektrem účinku, tzv. úzkospektrá antibiotika. Důvodem je, abychom zacílili na nejpravděpodobnější či prokázané původce infekce a snažili se ochránit přirozenou mikroflóru lidského těla. Naopak, když pacient má závažnou bakteriální infekce, je v ohrožení života a skončí na jednotce intenzivní péče, tak pak do doby, než zjistíme, jaká bakterie stav vyvolala, můžeme použít širokospektrá antibiotika. Tato situace ale opravdu nenastává u pacientů, kteří nejsou hospitalizováni.
Proč vlastně širokospektrá ATB neužíváme u všech pacientů a v čem spočívá jejich riziko?
Širokospektrá ATB by se měla indikovat jen v dobře odůvodněných případech, protože mohou mít více nežádoucích účinků a přispívají také k odolnosti bakterií na antibiotika, tedy k antibiotické rezistenci. Širokospektrá ATB bohužel ničí i bakterie, které jsou součástí přirozené mikroflóry a prospívají nám. Porušení mikroflóry střev může vést dokonce i k závažným infekcím, jako jsou střevní infekce vyvolané klostridiemi či infekce vyvolané kvasinkami. Proto se je snažíme v běžné ambulantní praxi neužívat.
Co si myslíte o krátkodobých ATB?
Obecně nový trend, který se objevuje i v našich doporučených postupech je snaha o zkracování délky antibiotické terapie. Například angina, která se dříve léčila 10 dnů, tak dnes může být zcela bezpečně léčena pouze 5 dnů. Právě zkrácení délky užívání antibiotik i snižuje riziko jejich nežádoucích účinků. Ale bohužel úplně jiná situace nastává u tzv. třídenního antibiotika (azitromycin). Toto antibiotikum, přestože je mezi pacienty a některými lékaři oblíbené, tak je díky svému dlouhodobému působení velmi rizikové z hlediska ovlivnění mikroflóry a šíření rezistence. Účinná látka totiž ovlivňuje bakterie i řadu dnů poté, co antibiotikum již neužíváme. Na tomto místě bych chtěl apelovat na pacienty, aby toto „oblíbené“ antibiotikum po svých lékařích nevyžadovali.
Jsou některá antibiotika šetrnější?
Ano, jednoznačně. Dokonce i Světová zdravotnická organizace mezi nimi rozlišuje. Jedno z nejšetrnějších antibiotik představuje penicilin a obecně antibiotika penicilinové řady. Tato antibiotika mají výrazně menší nežádoucí vliv na přirozenou mikroflóru. Bohužel řada pacientů uvádí, že na toto antibiotikum je alergická. Avšak reálně víme, že tento typ „alergie“ je výrazně nadhodnocen. Kolegové z Harvardovy univerzity prokázali, že více jak 90 % pacientů, kteří zmiňují, že měli vyrážku po penicilinu, toto antibiotikum budou tolerovat.
A jak je to s dobíráním ATB? Musím vždy všechna spotřebovat, i když už se cítím dobře?
Ukazuje se, že u řady infekcí lze bezpečně délku antibiotické terapie zkrátit. Proto v případě, že dojde k ústupu obtíží, je možné u běžných infekcí po poradě s lékařem antibiotickou terapii ukončit.
Více na www.antibiotickarezistence.cz. Realizátorem projektu Prevence antibiotické rezistence je Státní zdravotní ústav. Projekt Prevence antibiotické rezistence (ZD-PDP2-001) byl podpořen grantem z Fondů EHP 2014–2021 z programu Zdraví. www.eeagrants.cz.
Komentáře
- Pro vkládání komentářů se musíte registrovat nebo přihlásit
- Pro vkládání komentářů se musíte registrovat nebo přihlásit
- Pro vkládání komentářů se musíte registrovat nebo přihlásit
- Pro vkládání komentářů se musíte registrovat nebo přihlásit

- Pro vkládání komentářů se musíte registrovat nebo přihlásit
Pošli odkaz